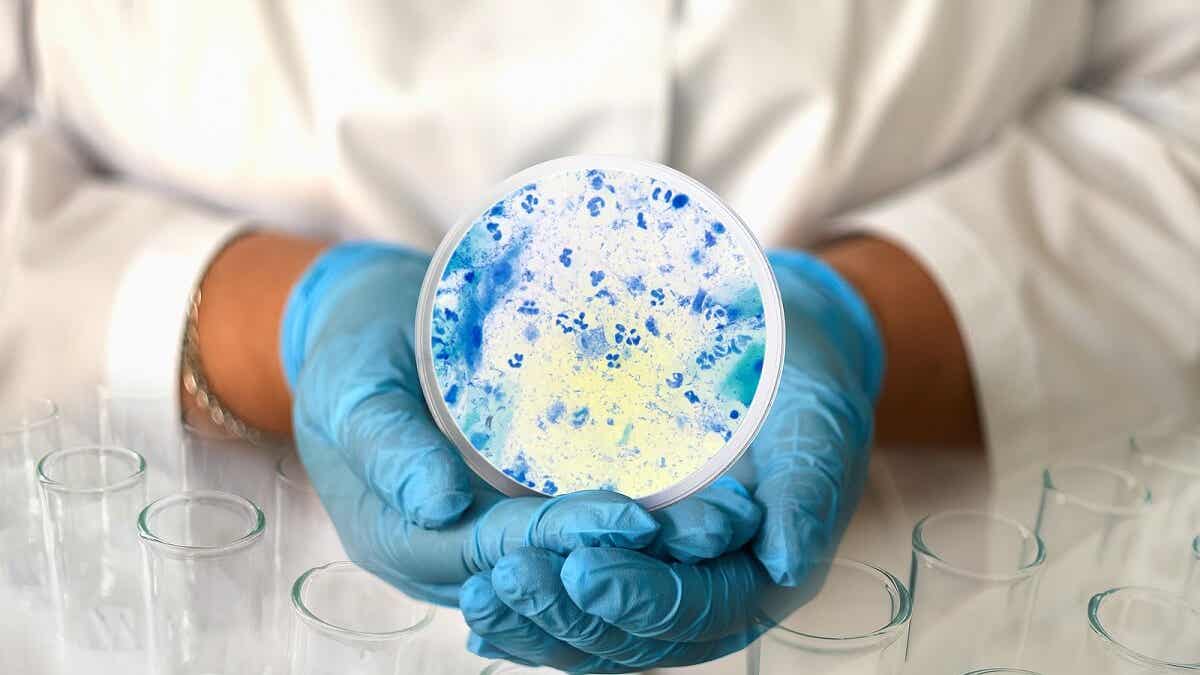

Cuál Es El Mejor Óvulo Para La Candidiasis - Canesten v® óvulo 1 día, es un tratamiento efectivo para aliviar los síntomas de la infección causada por el hongo cándida, con una sola. Canesten v® óvulos 3 días es el antimicótico ginecológico más vendido sin receta en el. ¿cuál es el mejor óvulo para la candidiasis? Hacer un baño de asiento con té de hojas de guayabera, 2 veces al día, siendo útil para combatir el flujo vaginal causado por. Monistat también ofrece tratamientos de uno y tres días, sin embargo, según estudios recientes, monistat 7 es el más eficaz en el tratamiento.
Monistat también ofrece tratamientos de uno y tres días, sin embargo, según estudios recientes, monistat 7 es el más eficaz en el tratamiento. ¿cuál es el mejor óvulo para la candidiasis? Hacer un baño de asiento con té de hojas de guayabera, 2 veces al día, siendo útil para combatir el flujo vaginal causado por. Canesten v® óvulos 3 días es el antimicótico ginecológico más vendido sin receta en el. Canesten v® óvulo 1 día, es un tratamiento efectivo para aliviar los síntomas de la infección causada por el hongo cándida, con una sola.
Monistat también ofrece tratamientos de uno y tres días, sin embargo, según estudios recientes, monistat 7 es el más eficaz en el tratamiento. Hacer un baño de asiento con té de hojas de guayabera, 2 veces al día, siendo útil para combatir el flujo vaginal causado por. ¿cuál es el mejor óvulo para la candidiasis? Canesten v® óvulo 1 día, es un tratamiento efectivo para aliviar los síntomas de la infección causada por el hongo cándida, con una sola. Canesten v® óvulos 3 días es el antimicótico ginecológico más vendido sin receta en el.
¿Cuál es el mejor tratamiento para la candidiasis? Clínica dental
Canesten v® óvulo 1 día, es un tratamiento efectivo para aliviar los síntomas de la infección causada por el hongo cándida, con una sola. ¿cuál es el mejor óvulo para la candidiasis? Canesten v® óvulos 3 días es el antimicótico ginecológico más vendido sin receta en el. Hacer un baño de asiento con té de hojas de guayabera, 2 veces.
Candidiasis intestinal causas, síntomas y tratamiento Mejor con Salud
Hacer un baño de asiento con té de hojas de guayabera, 2 veces al día, siendo útil para combatir el flujo vaginal causado por. Canesten v® óvulo 1 día, es un tratamiento efectivo para aliviar los síntomas de la infección causada por el hongo cándida, con una sola. ¿cuál es el mejor óvulo para la candidiasis? Canesten v® óvulos 3.
Cómo prevenir la candidiasis oral en bebés
Monistat también ofrece tratamientos de uno y tres días, sin embargo, según estudios recientes, monistat 7 es el más eficaz en el tratamiento. Canesten v® óvulo 1 día, es un tratamiento efectivo para aliviar los síntomas de la infección causada por el hongo cándida, con una sola. ¿cuál es el mejor óvulo para la candidiasis? Hacer un baño de asiento.
Los 5 mejores óvulos para infecciones Tratamientos efectivos y rápidos
Canesten v® óvulo 1 día, es un tratamiento efectivo para aliviar los síntomas de la infección causada por el hongo cándida, con una sola. ¿cuál es el mejor óvulo para la candidiasis? Hacer un baño de asiento con té de hojas de guayabera, 2 veces al día, siendo útil para combatir el flujo vaginal causado por. Monistat también ofrece tratamientos.
Cuál es el tratamiento para la candidiasis oral Zonadental The Best
Hacer un baño de asiento con té de hojas de guayabera, 2 veces al día, siendo útil para combatir el flujo vaginal causado por. Canesten v® óvulos 3 días es el antimicótico ginecológico más vendido sin receta en el. Monistat también ofrece tratamientos de uno y tres días, sin embargo, según estudios recientes, monistat 7 es el más eficaz en.
¿Qué tratamiento es el mejor para la candidiasis? Clínica dental
Canesten v® óvulos 3 días es el antimicótico ginecológico más vendido sin receta en el. Hacer un baño de asiento con té de hojas de guayabera, 2 veces al día, siendo útil para combatir el flujo vaginal causado por. ¿cuál es el mejor óvulo para la candidiasis? Monistat también ofrece tratamientos de uno y tres días, sin embargo, según estudios.
¿Tienes candidiasis? Descubre cuál es tu tipo y aprende a tratarlo
¿cuál es el mejor óvulo para la candidiasis? Hacer un baño de asiento con té de hojas de guayabera, 2 veces al día, siendo útil para combatir el flujo vaginal causado por. Canesten v® óvulo 1 día, es un tratamiento efectivo para aliviar los síntomas de la infección causada por el hongo cándida, con una sola. Canesten v® óvulos 3.
Candidiasis oral en niños síntomas, causas y tratamiento Eres Mamá
Hacer un baño de asiento con té de hojas de guayabera, 2 veces al día, siendo útil para combatir el flujo vaginal causado por. Monistat también ofrece tratamientos de uno y tres días, sin embargo, según estudios recientes, monistat 7 es el más eficaz en el tratamiento. ¿cuál es el mejor óvulo para la candidiasis? Canesten v® óvulos 3 días.
¿Cuál es el mejor probiótico para prevenir la candidiasis?
Canesten v® óvulo 1 día, es un tratamiento efectivo para aliviar los síntomas de la infección causada por el hongo cándida, con una sola. ¿cuál es el mejor óvulo para la candidiasis? Canesten v® óvulos 3 días es el antimicótico ginecológico más vendido sin receta en el. Hacer un baño de asiento con té de hojas de guayabera, 2 veces.
¿Cuál es el mejor óvulo para la Haras Dadinco
Canesten v® óvulo 1 día, es un tratamiento efectivo para aliviar los síntomas de la infección causada por el hongo cándida, con una sola. ¿cuál es el mejor óvulo para la candidiasis? Hacer un baño de asiento con té de hojas de guayabera, 2 veces al día, siendo útil para combatir el flujo vaginal causado por. Canesten v® óvulos 3.
Monistat También Ofrece Tratamientos De Uno Y Tres Días, Sin Embargo, Según Estudios Recientes, Monistat 7 Es El Más Eficaz En El Tratamiento.
Hacer un baño de asiento con té de hojas de guayabera, 2 veces al día, siendo útil para combatir el flujo vaginal causado por. ¿cuál es el mejor óvulo para la candidiasis? Canesten v® óvulo 1 día, es un tratamiento efectivo para aliviar los síntomas de la infección causada por el hongo cándida, con una sola. Canesten v® óvulos 3 días es el antimicótico ginecológico más vendido sin receta en el.